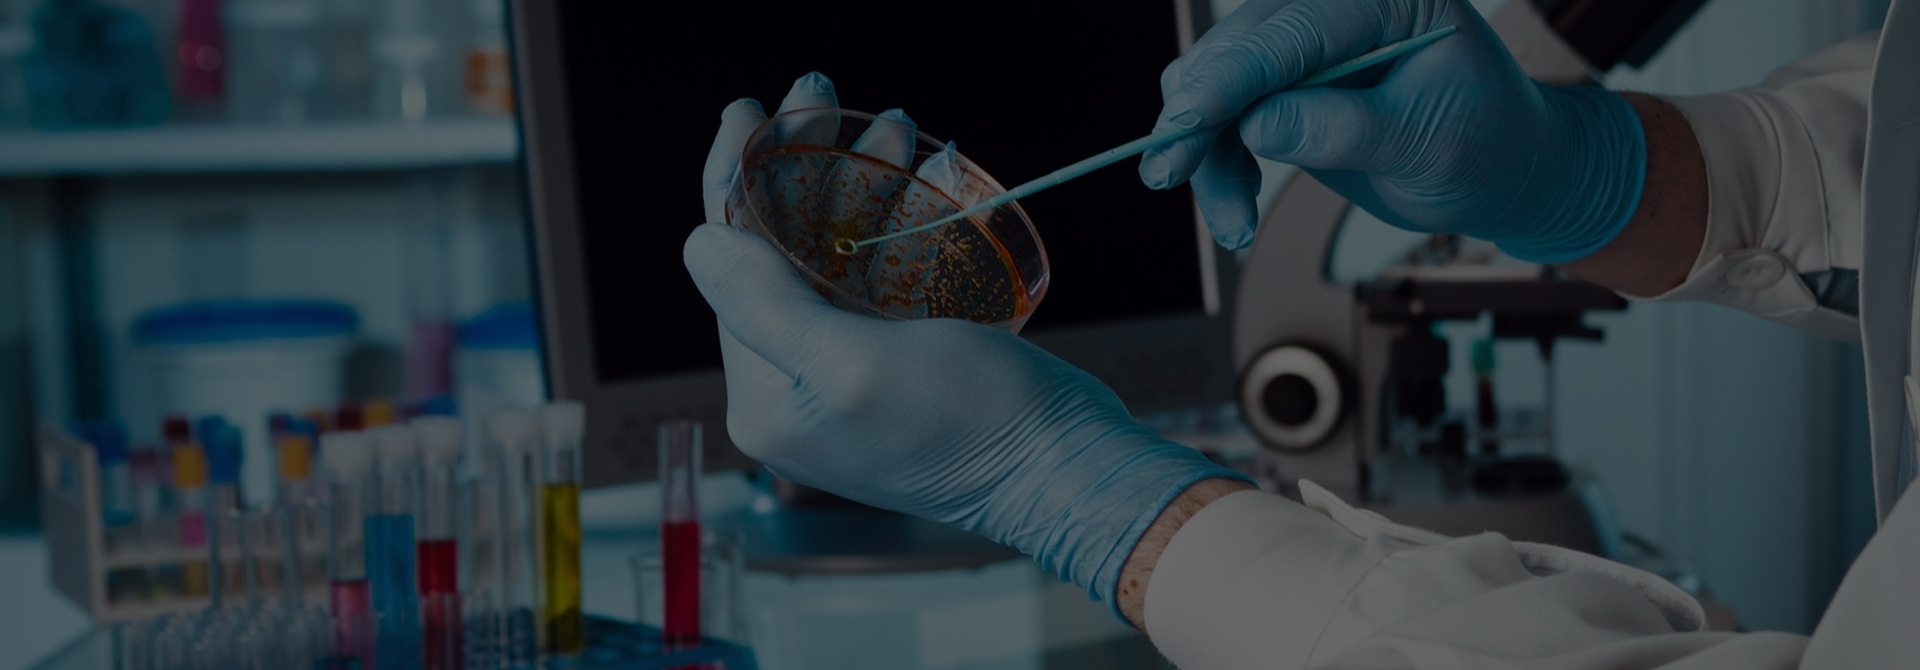

Henotic Pharma
Making you more healthy!
Henotic Pharma is a marketing based pharmaceutical company with its main focus on making available quality pharmaceutical products at affordable costs to all. Our purpose is helping people live longer, healthier and happier lives.
SPECIALTIES
Our Products
Henotel 20
Henotel 40
Henotel-H
Henotel Beta 25
Henotel Beta 50
Henotel-LN 10
Henotel-CT 40
Henotel AM
Henovit
Quality Policy
Our Quality Speaks
Quality and Henotic Pharma are synonymous! For us, patient satisfaction is the foundation on which the organization rests. Our every action is triggered by empathy for patients and the unflinching commitment to fulfil their unmet needs. This helps us focus on creating apex quality products to address the needs of patients.
OUR FEATURES
Our excellent team is ready to be part of your team to work into the different areas

INTEGRITY
We conduct ourselves with uncompromising integrity and honesty and insist on the highest ethical standards and transparency from our employees in all interactions. Everything we do must stand public scrutiny.

PASSION FOR EXCELLENCE
We relentlessly pursue excellence through innovation and continuous improvement in all our projects, processes and products. To set our standards, we benchmark with one of the best in the World.

TEAMWORK
We align efforts and energies of our people across all levels and geographies to deliver outstanding results to our stakeholders. We encourage diverse opinions and work together in a mutually supportive way.